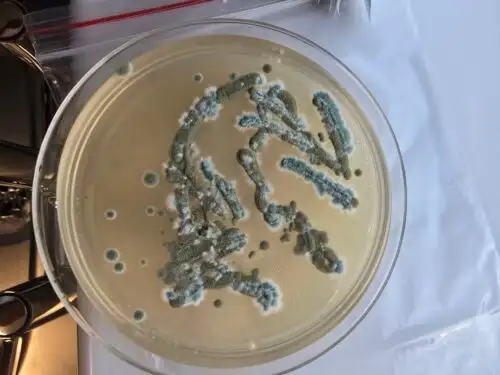
mold testing voodvile

Trusted Mold Inspection and testing Specialists in Woodville
Worried about mold sneaking into your home in Woodville? We’re providing mold inspection Woodville services here to keep your family safe. Our certified crew uses cool gadgets like thermal imaging for checking for mold in houses to hidden mold in walls or under floors. Florida’s muggy air loves to grow that nasty stuff, but we catch problems before they wreck your house or make you cough. Grab your phone and call today!



Affordable Prices
No hidden charges, reliable and honest service
100% Satisfaction
Your safety and peace of mind are our top priorities.
Same-Day service
Same day services Call today and we’re on the way
Our services
Mold Inspection Woodville
In Woodville, it’s easy to overlook that faint, musty smell — until it creeps into every room. We’ve helped families around Oak Ridge Road and Woodville Highway catch mold hiding in crawlspaces, under vinyl, and even behind kitchen cabinets. Our inspections aren’t guesswork. We show you exactly what’s going on, using tools that see what your eyes can’t.
We live nearby — and we care like neighbors. Let’s check it out together before small mold turns into big damage. If you’re in Bradfordville, schedule your specialized mold inspection in Bradfordville to catch hidden growth early.
Call us for a quote today!
+1 (850) 299-1274

Mold Testing Woodville
One Woodville homeowner thought her cough was just allergies — until our air test told a different story. That’s the thing about mold: you don’t always see it, but your body knows. We test for airborne spores, surface growth, and hidden colonies using certified labs. No drama, just the facts — and a plan. If something feels off in your home, trust your gut. Let’s get real answers with mold testing you can count on.
Call us for a quote today!
+1 (850) 299-1274
Basement Mold Removal Woodville
That damp, earthy smell in your Woodville basement? It’s not just an old house. It’s probably mold. We’ve cleaned up basements with soaked drywall, crumbling insulation, and years of hidden growth — all while keeping the structure and story of the home intact. We’re not just here to remove mold; we’re here to make sure it doesn’t come back. If your basement’s been holding its breath, we’ll help it breathe again.

Call us for a quote today!
+1 (850) 299-1274

HVAC Mold Removal Woodville
Mold in your HVAC doesn’t just stay in the vents — it follows you into every room. We’ve helped Woodville families clear mold from AC coils, ductwork, and filters, especially in homes that sit empty part of the year. It’s not about cleaning — it’s about protecting your air, your lungs, and your peace of mind. If your home air smells off, let’s get inside that system and fix it for good.
Call us for a quote today!
+1 (850) 299-1274
Bathroom Mold Removal Woodville
In Woodville’s older homes, we’ve seen mold growing behind bathroom tiles like it’s been there for years — quiet but harmful. We’ve removed it safely, rebuilt where needed, and made sure it never came back. Our work doesn’t just clean surfaces — it protects your family’s health and your home’s value. If your bathroom feels damp and you’re scrubbing the same spots over and over, let’s solve it right — not just cover it up.

Call us for a quote today!
+1 (850) 299-1274
These guys came out the same week and walked us through everything with zero pressure. They treated our home like their own — even helped with tips to prevent future moisture issues.

Emily Carter
near Oak Ridge Rd, Woodville
This team was different, they showed up on time, explained everything in plain language, and got the job done right. Living in Woodville, you need someone who gets the local climate and they truly do.

Marsha T
Woodville, Florida
testimonials
What our clients says about us
Homeowners in Woodville trust us for fast, honest service. They appreciate how we explain each step clearly and keep them informed.
Contact Us
Make An Appointment
Schedule your mold inspection today! Our certified inspectors use advanced tools to detect mold and ensure your home’s safety. Call now for air quality testing and remediation guidance
Call us for a quote today!
+1 (850) 299-1274
